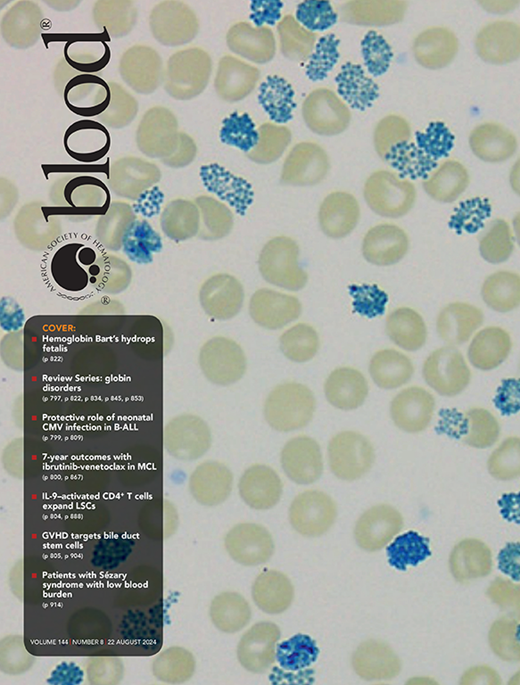
Blood Cover Image for Volume 144, Issue 8

In this issue of Blood, Handunnetti et al1 present a 7-year follow-up of their previously reported2 phase 2, investigator-initiated clinical trial (the AIM trial) assessing the combination of ibrutinib and venetoclax in patients with mantle cell lymphoma (MCL), most of whom had relapsed or had refractory disease. In this updated report, they highlight the long-term benefit and the results of a protocol amendment allowing patients in confirmed measurable residual disease (MRD)-negative complete remissions to stop therapy after a 1-year minimum of combination treatment.
MCL remains a challenging non-Hodgkin lymphoma to treat, as it harbors features of aggressive lymphomas, yet remains largely incurable. However, targeted agents and T-cell-engaging therapy are redefining treatment paradigms and extending survival. Additionally, MRD is an emerging biomarker in mantle cell but has not yet made its way into standard clinical practice.
Considering this changing landscape, the authors provide long-term follow-up of the ibrutinib-venetoclax combination, reporting an impressive 7-year progression-free survival (PFS) of 30%, with a median duration of response of 81 months in the study population. Notably, there were early progressions or refractory disease in several patients with TP53 aberrations, particularly when coupled with SMARCA2/SMARCA4 baseline variants, which their group has previously described as a mechanism of ibrutinib and venetoclax resistance.3
In their original publication, they reported a complete response (CR) rate of 62% and 67% being undetectable for residual disease in the marrow. Given this, the protocol was amended to allow those achieving both end points to stop treatment after a minimum of a year on therapy. These patients were carefully monitored for progression, with MRD via peripheral blood flow cytometry performed monthly as well as frequent radiographic assessments. These 8 patients represented a relatively high-risk group with a median of 4 lines of prior therapy and 50% with a high mantle cell lymphoma international prognostic index (MIPI) score. They entered the elective treatment interruption at a median of 23 months, although most achieved a CR with undetectable MRD much earlier (see figure). Interestingly, the patents had a median time in remission of 58 months, with 4 ultimately progressing, 2 of whom had TP53 alterations. Of these 4 patients, 3 were able to resume treatment, 2 of whom (both with TP53 alterations) quickly achieved a second complete response. The authors conclude that there is indeed synergy as posited in preclinical data4 and additional clinical benefit compared with sequential use.5-7 These results demonstrate that a BTK- and BCL2-targeted retreatment strategy incorporating treatment holidays is feasible.
PFS for patients with relapsed or refractory MCL treated with ibrutinib and venetoclax. Curves are from 2 separate trials superimposed in a single Kaplan-Meier plot. Professional illustration by Somersault18:24.
PFS for patients with relapsed or refractory MCL treated with ibrutinib and venetoclax. Curves are from 2 separate trials superimposed in a single Kaplan-Meier plot. Professional illustration by Somersault18:24.
It is important to interpret these results in the setting of the recently presented SYMPATICO trial,5 which randomized patients to ibrutinib and venetoclax vs ibrutinib with placebo; patients continued on the combination for 2 years before transitioning to ibrutinib monotherapy until progression. SYMPATICO showed that the combination improved PFS (median 31.9 vs 22.1 months) and complete remission rates (54% vs 32%), but without statistically significant improvement in overall survival to date. There was also a higher incidence of grade ≥3 toxicity (84% vs 76%) in the combination arm. With all the caveats of comparing 2 different trials and acknowledging the relatively small number of patients treated on AIM, the 2 studies show a similar PFS for patients with relapsed or refractory MCL receiving the combination of ibrutinib and venetoclax, suggesting that treatment interruptions may not lead to inferior efficacy in this population (see figure).
As promising as these results appear, applying a retreatment strategy to individual patients is challenging at the current time. Although some patients were able to enjoy durable remissions off treatment, the short median PFS in TP53 aberrant patients suggests continuous use of targeted agents may be required for most patients with TP53 dysfunctional MCL. The lack of response in patients with SMARCA4 mutation suggests that alternative therapies, perhaps including T-cell-engaging therapies, may better serve the highest-risk patients. Data combining venetoclax with next-generation BTK inhibitors are also needed, particularly in light of the recent voluntary Food and Drug Administration withdrawal of the mantle cell indication for ibrutinib8 and the improved safety profiles for acalabrutinib, zanubrutinib, and pirtobrutinib. Although it is premature to broadly apply the these results to clinical practice, AIM does set the stage for future studies investigating an MRD-guided precision approach, including the AIM2 (NCT05864742) and TRAVERSE (NCT05951959)9 trials as well as randomized studies incorporating treatment interruptions into BTK inhibition-based therapy (NCT05976763). These efforts will test the noninferiority of a retreatment approach and provide additional data eventually allowing clinicians to use MRD-guided time-limited therapy.
The AIM authors are to be commended for their efforts, which have provided the field with valuable information as to the role of MRD-guided combinatorial treatment in this challenging patient population and will guide development of future clinical trials. We look forward to the ongoing attempts to place relapsed MCL in the crosshairs of targeted therapies.
Conflict-of-interest disclosure: D.S.W. reports no competing financial interests. P.M.B. reports consulting for AbbVie, Adaptive Biosciences, AstraZeneca, BeiGene, BMS, Eli Lilly, Genentech Janssen, Merck, Morphosys, Seattle Genetics, and TG Therapeutics.